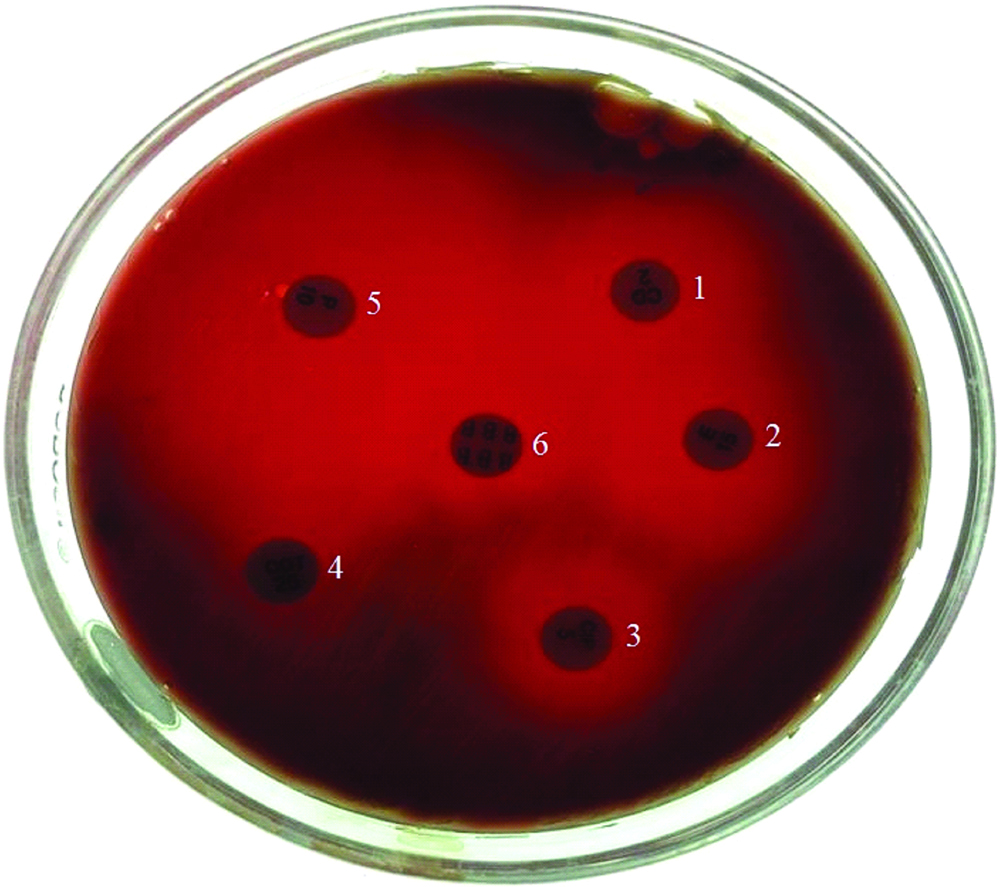

Sore throat is one of the important reasons for visit to paediatricians. Viruses are the causative agents in two third of sore throats among children and Streptococcal pharyngitis in one third [1,2]. Streptococcus pyogenes, the leading bacterial cause, accounts for 15-30% of cases in children [3]. Viral sore throats are often self-limiting while Streptococcus pyogenes causes several suppurative and non-suppurative complications if not treated in time [1,4]. Suppurative complications include otitis media, sinusitis, peritonsillar abscess, retropharyngeal abscesses and cervical adenitis. Non-suppurative complications include Acute Rheumatic Fever (ARF), and Streptococcal Glomerulonephritis. Rheumatic heart disease is the most high-risk sequelae. The prevalence of rheumatic heart disease varies from 1 to 5.4/1,000 amongst school age children [2,4].
Diagnosis and treatment of streptococcal pharyngitis is important because antimicrobial therapy initiated within time leads to rapid resolution of illness and is effective in preventing suppurative and non-suppurative complications. Differentiating streptococcal pharyngitis from that of a viral aetiology, and adequate treatment can help the clinician effectively prevent post-streptococcal sequelae [4,5].
Considering, the non-specific symptoms, risk of hypersensitivity to parenteral penicillin, non-availability and long course of oral penicillin physicians always choose oral antibotics like the Macrolide group of antibiotics in treatment of sore throat [1,6].
Materials and Methods
A cross-sectional study was conducted at Acharya Vinoba Bhave Rural Hospital and Jawaharlal Nehru Medical College, Wardha, Maharashtra, India, over a period of two months from June 1st 2016 to July 31st 2016. Study participants were 200 children of 5-12 years attending paediatric OPD and clinically diagnosed as sore throat. Participants were selected by simple random sampling.
Exclusion criteria were children taking antibiotics, or who had received antibiotics in the past two weeks of collection of throat swab, the cases diagnosed of acute rheumatic fever, cases with tonsillectomy done and those suffering from any chronic illness.
Study was done with permission from the Institutional Ethical Committee, Ref No. DMIMS (DU)/IEC/2015-16/4864.
Written consent was then obtained and a proforma detailing age, sex, health status and other relevant data about the participant was collected from participant’s parents.
Collection of Throat Swabs
Cotton swabs sterilised by hot air oven at 160°C for 1 hour were used. Sterilised swabs moistened with Amie’s medium, were rubbed very well by rotating over both the tonsils and posterior pharyngeal wall [10]. Two swabs were collected from each participant.
Processing of Throat Swabs for Isolation and Identification
Throat swab was immediately cultured on Crystal violet blood agar containing Crystal violet 1 mg/L, nalidixic acid 15 mg/L, colistin sulphate 10 mg/L, and 5% sterile defibrinated sheep blood, as it is a selective medium for Streptococcus pyogenes. Throat swab II was cultured on 5% Blood agar. The swabs were rolled on one third of the plate and then inoculated by “streak and stab” technique. In streak and stab technique some of the inoculum was forced under the agar to create a relatively anaerobic environment. Areas of the plate not inoculated with specimen were stabbed. The culture plates were incubated at 37°C in 5-10% CO2 (Candle jar), for 24-hours in the incubator. β-Haemolytic, pinpoint, grayish colonies as depicted in [Table/Fig-1], which are Catalase negative and Gram positive cocci in chains on Gram staining were tested further. These colonies were subcultured on 5% sheep blood agar as per conventional streak culture technique. Susceptibility to 0.04 U Bacitracin disk and SXT disc (Trimethoprim 1.25 μg and Sulfamethoxazole 23.75 μg) was checked by putting Bacitracin disk on well and SXT disc on primary streak line. Streptococcus pyogenes are known to be sensitive to low concentration of Bacitracin and resistant to SXT. Thus, for purposes of inference, an inhibition zone of >15 mm around the Bacitracin disk, and no zone around SXT was taken to be confirmatory.
Beta-Haemolytic, pinpoint, greyish colonies observed on blood agar (black arrow).

Antibiotic Susceptibility Testing
All the Streptococcus pyogenes isolates were subjected to in -vitro antibiotic susceptibility testing on Muller-Hinton agar with 5% sheep blood as per CLSI guidelines 2014 [11], as depicted in [Table/Fig-2].
Isolates showing Antibiotic susceptibility pattern to Clindamycin (1) Erythromycin (2) Ciprofloxacin (3) Cotrimoxazole (4) Penicillin (5) and Bacitracin (6).
Macrolide resistance phenotypes were identified using a double disc test with erythromycin (15 μg) disc and clindamycin (2 μg) disc. Erythromycin (15 μg) disc was placed at a distance of 15 mm (edge to edge) from clindamycin (2 μg).
Isolates showing resistance to erythromycin (zone size ≤15 mm), and sensitivity to clindamycin (zone size ≥19 mm) were considered to be Clindamycin susceptible phenotype (MS). Inducible clindamycin resistance phenotype (MLSBi) were isolates showing resistance to erythromycin having zone size ≤15 mm, yet which were sensitive to clindamycin as seen by zone size ≥19 mm, and produced a D shaped zone of inhibition around the clindamycin disc, which flattens towards the erythromycin disc. Hazy growth within the zone of inhibition around clindamycin even if no D-zone is apparent was taken to be clindamycin resistance. Isolates showing resistance to erythromycin (zone size ≤15 mm) and clindamycin (zone size ≤15 mm) were considered to be Constitutive clindamycin resistance phenotype (MLSBc).
Control strain used was Streptococcus pyogenes ATCC 1961.
Statistical Analysis
The data obtained was entered in MS-Excel and analysed using IBM-SPSS Statistics-2015. Tables and diagrams were included to represent the same.
Results
A total of 200 throat swabs were collected and examined for the study over a period of two months. Of the participants, 84 (42%) were boys, and 116 (58%) were girls. The prevalence of Streptococcus pyogenes infection in sore throat cases was 5.5% (11/200), with 6 study participants (54.5%) being girls and 5 participants (45.4%) being boys. The patients who tested positive for Streptococcus pyogenes were from the age group of 7 to 11-year-old.
The most common additional symptoms in children with Streptococcus pyogenes sore throat were cough and fever, that 11 out of 11 (100%) children presented with. Four out of 11 children (36.3%) had cervical lymphadenopathy on examination, while one child (9.09%) had generalised swelling of tonsils and formation of exudates as well.
When subjected to antibiotic susceptibility testing, 11/11(100%) isolates were found to be sensitive to Penicillin, Clindamycin, Ciprofloxacin, and Cefotaxime by disc diffusion method, with 11/11 (100%) being resistant to Cotrimoxazole (Sulfamethoxazole-Trimethoprim), confirmed by no inhibition of growth around the SXT disc, as is depicted in [Table/Fig-3]. A 2/11 (18.18%) isolates were also found to display resistance to Macrolide, 2/2 (100%) being MS phenotype. Amongst isolates displaying resistance to Macrolides, no isolates demonstrating MLSBi or MLSBc phenotype were obtained.
Sensitivity pattern of Streptococcus pyogenes isolates.
| Antibiotic | Penicillin | Clindamycin | Erythromycin | Ciprofloxacin | Cefotaxime |
|---|
| n=11 | 11 | 11 | 09 | 11 | 11 |
| % | 100 | 100 | 81.81 | 100 | 100 |
Discussion
Differentiating streptococcal pharyngitis from viral pharyngitis is important for treatment. An adequate treatment of streptococcal pharyngitis leads to more rapid resolution of illness and is effective in preventing life threatening non-suppurative complications such as acute rheumatic fever and acute glomerulonephritis. Similarly, avoiding unnecessary use of antibiotics in viral pharyngitis prevents the emergence of antibiotic resistance.
In this study, we evaluated throat swabs from 200 children aged 5-12 years, who presented to the Paediatrics OPD with sore throat. On review of literature, the prevalence of Streptococcus pyogenes infection in symptomatic cases: 5.5% (11/200), was found to be almost in consistence with other studies conducted in India, which had reported prevalence ranging from 10% in Tamil Nadu back in 2003 [12], to a study from Manglore in 2014, which reported 5% [2]. The patients who tested positive for Streptococcus pyogenes were from the age group of 7 to 11-year-old.
All the patients with Streptococcus pyogenes sore throat had complaint of cough and fever while 4/11 patients had cervical lymphadanopathy. Tonsillar swelling and exudate formation was seen in 1/11, while none had white patch over the peri-tonsillar area or posterior pharyngeal wall. In comparision, most common clinical features were a temperature greater than 100.4°F (38°C) and tonsillar exudates in a study undertaken at Haryana [13]. This can probably be attributed to changing clinical patterns of streptococcal pharyngitis.
Penicillin is the drug of choice for the treatment of streptococcal pharyngitis, with the low cost, narrow spectrum of activity and excellent safety record in those who are not allergic to penicillin, being added advantages. For penicillin allergic individuals the alternative therapies includes Macrolide, first generation cephalosporins and clindamycin.
In the present study, all the isolates were sensitive to penicillin by disc diffusion method. This finding correlates with finding obtained in studies from New Delhi [14] and Imphal [3]. Penicillin sensitivity was 91.3% in study from Kolkata [7]. Present study finding of 100% sensitivity to Cefotaxime correlates with reports from Manglore and Kolkata [2,7]. Sensitivity to other antibiotics including Clindamycin and Ciprofloxacin was also found to be 100% in the present study.
Erythromycin resistance was found in 18.18% (2/11) which was comparable to other studies from New Delhi, Korea and Egypt [8,14,15]. Comparatively higher resistance (38.6%) was reported in study from Imphal [3]. In the present study, 2/2 isolates (100%) which showed Macrolide resistance were found to have MS phenotype, and no isolates showing MLSBi or MLSBc phenotype were obtained, but other studies reported in national literature have documented growth of constitutive phenotype MLSBc and inducible phenotype MLSBi as well [8,9,15]. Thus, a major point of concern was this Macrolide resistance that was documented.
The results obtained emphasize the need of continuous surveillance to access the epidemiology of Streptococcus pyogenes pharyngitis. The data will help in proper treatment and thus reducing morbidities due to complications of Streptococcus pyogenes infection.
Limitation
As the study was carried out within a time-frame of two months, follow-up of patients was a key component that needs to be assessed in future studies. Also, a larger study population obtained over a longer period of time can give a more accurate representation of antibiotic susceptibility and resistance amongst various strains today. Including ASO titres can help diagnose patients suffering from Rheumatic Heart Disease quickly, thus paving the way for more intensive antibiotic regimes, and thus should be included in a larger, multi-centric study.
Conclusion
Even though the antibiogram pattern of Streptococcus pyogenes hasn’t changed significantly regarding susceptibility to Penicillin, the erythromycin resistance of two isolates obtained is a cause of concern that should be addressed urgently. Thus, this study highlights the need for culture-specific treatment and monitoring, a practice that should be strictly carried out across all Tertiary Care Centre today in India.